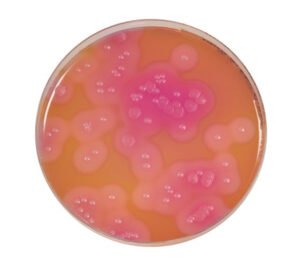
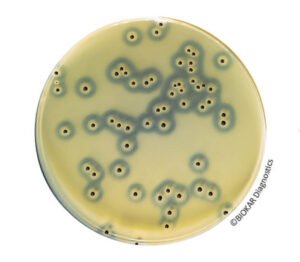
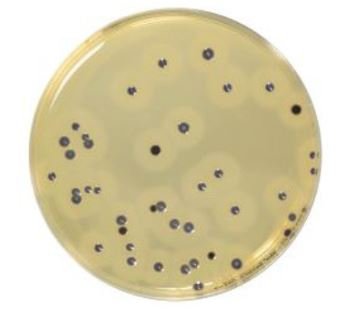
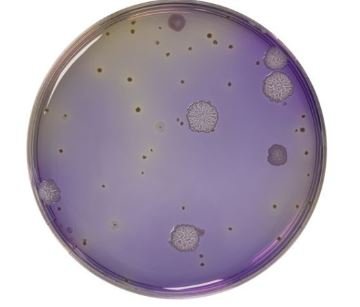
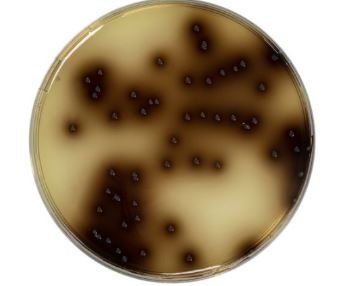
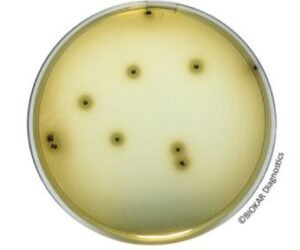
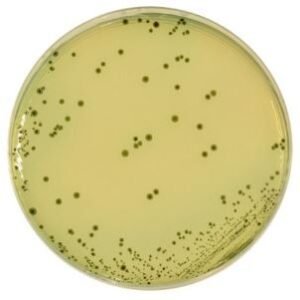
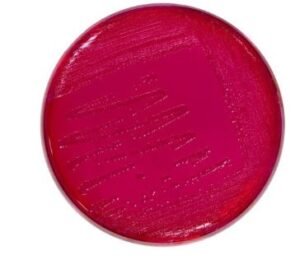
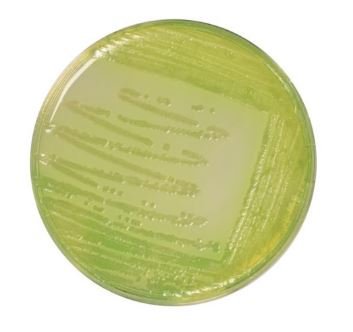
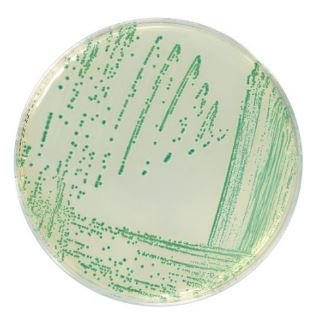
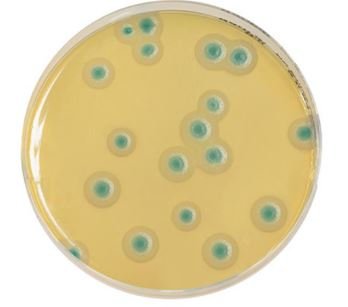
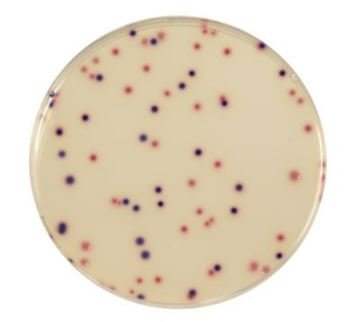
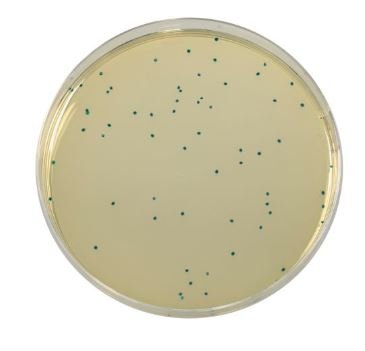
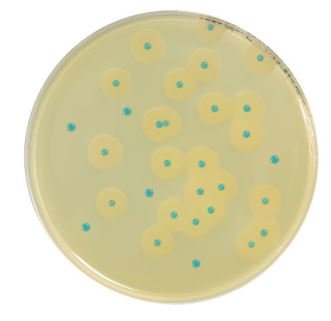
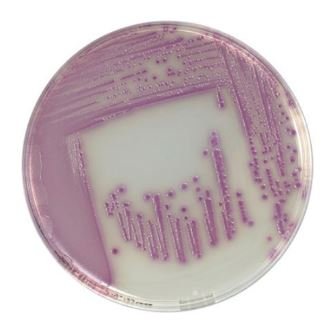
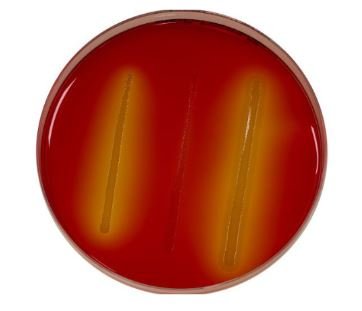
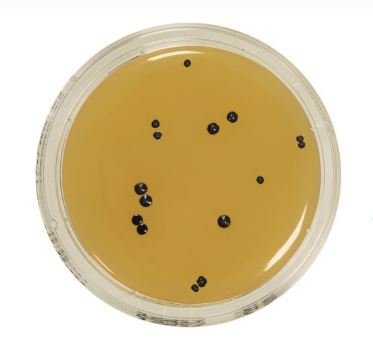
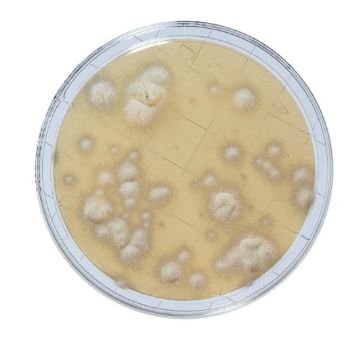
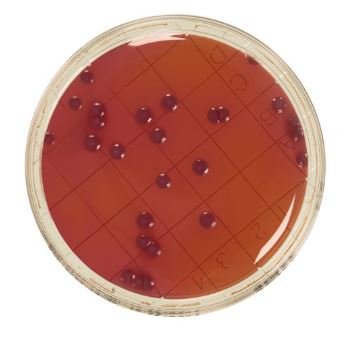
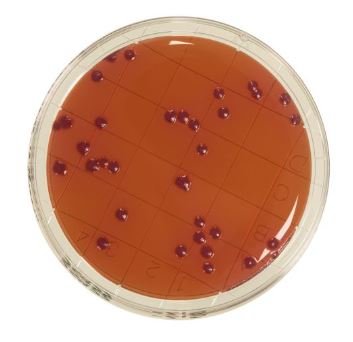
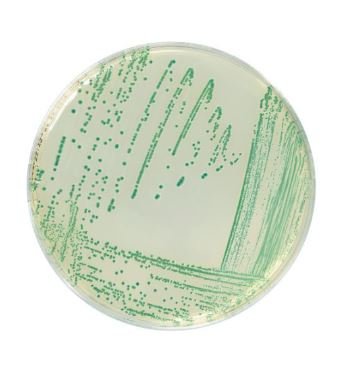

Alkaline saline peptone water (ASPW) is used as a primary and secondary enrichment medium for the detection of Vibrio spp. in human and animal food products as well as environmental samples.
The typical composition meets food microbiology standards XP ISO/TS 21872-1 and XP ISO/TS 21872-2.
Food
- Animal Health
- Cosmetic
- Food
- Rapid methods
- Water and environments
- Presentation
- Microorganism

Alkaline Saline Peptone Water (ASPW)

Packaging
Dehydrated medium:
BK219HA – 500 g bottle
Azide Dextrose Broth (Acc. to Rothe)

Azide Dextrose Broth (Rothe) is used for the enumeration of enterococci in drinking water, frozen foods and other food products by the most probable number method.
Packaging
Dehydrated medium :
BK060HA – 500 g bottle
Bacillus Cereus Agar (Acc. to Mossel)
Bacillus cereus Agar is used for the detection and enumeration of spores and vegetative cells of Bacillus cereus in food products.
The typical composition corresponds to the MYP agar (mannitol, egg yolk, polymyxin agar) described in the standards NF EN ISO 7932 and NF EN ISO 21871.
Packaging
Ready-to-use medium :
BM03808 – 20 Petri plates Ø 90 mm
BM19908 – 120 Petri plates Ø 90 mm
Dehydrated base medium :
BK116HA – 500 g bottle
Sterile egg yolk emulsion with Polymyxin B :
BS05508 – 10 vials of 50 mL
Sterile egg yolk emulsion :
BS06608 – 10 vials of 50 mL
Selective supplement Polymyxin B :
BS00708 – 10 vials
Baird-Parker Agar With Egg Yolk Tellurite
Baird-Parker Agar with egg yolk and potassium tellurite is a selective medium for the detection and enumeration of Staphylococcus aureus in animal origin biological samples, pharmaceutical products, cosmetics, foods and water.
Ready-to-use medium :
BM01808 – 20 Petri plates Ø 90 mm
BM09108 – 120 Petri plates Ø 90 mm
Dehydrated base medium (without egg yolk or tellurite) :
BK055HA – 500 g bottle
BK055GC – 5 kg drum
Sterile Egg yolk emulsion with Potassium tellurite :
BS06008 – 10 vials of 50 mL
BS03608 – 1 vial of 900 mL
Sulfamethazine 25 mg supplement :
BS02808 – 10 vials qsp 500 mL
Baird-Parker RPF Agar
Baird Parker RPF (RPF = Rabbit Plasma Fibrinogen) Agar is used for the direct detection and enumeration of coagulase positive staphylococci. The medium has the advantage of considerably reducing the number of confirmation tests for the presence of coagulase positive staphylococci particularly when atypical colonies are observed on other selective media. The medium allows the simultaneous enumeration and confirmation to be performed in a single operation.
Packaging
Ready-to-use medium :
BM06708 – 20 Petri plates Ø 90 mm
BM15908 – 20 Petri plates Ø 55 mm
KIT :
BT00508 – 6 vials of 90 mL of base media and 6 RPF freeze-dried supplements
BT01008 – 6 vials of 190 mL of base media and 6 RPF freeze-dried supplements (BS075)
Dehydrated base medium :
BK055HA – 500 g bottle
BK055GC – 5 kg drum
Rabbit Plasma Fibrinogen Supplement :
BS03408 – 8 vials qsp 100 mL
BS03808 – 1 vial qsp 500 mL
BCP Dextrose Agar
BCP Dextrose Tryptone Agar (also known as BCP Glucose agar) is used to enumerate mesophilic and thermophilic aerobic bacterial spores (especially Bacillus stearothermophilus, responsible for flat sour) in raw materials and in ingredients used in canning non-acid products (pH > 4,5). It is also used in surface samples and canning process water.
Packaging
Ready-to-melt medium :
BM16808 – 10 vials of 200 mL
Dehydrated medium :
BK042HA – 500 g bottle
Bea Agar (Bile, Esculin & Azide)
Bile Esculin Azide Agar (BEA agar) is a selective medium used to isolate and enumerate enterococci in food and pharmaceutical products. It is also used for the enumeration of enterococci animal feed.
Packaging
Ready-to-melt medium :
BM10408 – 10 vials of 100 mL
Dehydrated medium:
BK158HA – 500 g bottle
Bismuth Sulfite Agar
Bismuth Sulfite (modified Wilson Blair agar) Agar is a selective medium used to isolate Salmonella Typhi and other salmonellas in pathological products of animal origin, water, dairy and other food products. Bismuth Sulfite agar can be used in the normalized methods for Salmonella detection as the second isolation media.
The typical composition corresponds to that defined in the standards NF EN ISO 6579, NF EN ISO 6785 and NF EN ISO 19250.
Packaging
Dehydrated medium :
BK004HA – 500 g bottle
Bismuth Sulfite Agar (ISO 6579-1)
Bismuth Sulfite Agar ISO 6579-1 is a selective medium used to isolate Salmonella in water, dairy products and other food products.
This medium is particularly used for the detection of Salmonella enterica subspecies enterica serovars Typhi and Paratyphi in human consumption and the feeding of animals, environmental samples and samples from the primary production stage.
Bismuth Sulfite agar can be used in the normalized methods for Salmonella detection as the second isolation media.
The typical composition corresponds to that defined in the standards NF EN ISO 6579-1.
Packaging
Dehydrated medium :
BK223HA – 500 g bottle
Brain-Heart Agar

Brain Heart agar is suitable for the culture of a large variety of microorganisms including yeasts & molds. After addition of sheep’s blood, the media is used for the culture of fastidious bacteria in a veterinary domain. After addition of gentamycin and chloramphenicol, a selective media is obtained that is suitable for the culture of pathogenic fungi in heavily contaminated bacterial samples and saprophytic molds. In light of its glucose content, the media is not suitable for the characterization of hemolysis.
Packaging
Dehydrated medium :
BK029HA – 500 g bottle
Brain-Heart Broth

Brain-Heart Broth is a buffered nutrient medium used for the culture of a wide variety of aerobic and anaerobic microorganisms including yeasts and molds. It is suitable for the detection of staphylocoagulase.
Packaging
Dehydrated medium :
BK015HA – 500 g bottle
Brilliant Green Agar (Edel & Kampelmacher)
Brilliant Green agar according to Edel & Kampelmacher is a selective medium used to isolate Salmonella in milk and dairy products.
This media can also be used as a second isolation media in the context of the various normalized methods for the detection of Salmonella spp.
Packaging
Dehydrated medium :
BK091HA – 500 g bottle
Brilliant Green Agar (Kristensen)

Brilliant Green Agar of Kristensen is a highly selective medium used to isolate salmonella, except for Salmonella Typhi, in biological samples of animal origin and food products.
The agar can also be used as the second media of choice in the normalized standards for the research and detection of Salmonella.
Packaging
Dehydrated medium :
BK071HA – 500 g bottle
Brilliant Green Bile Broth (BGBB)

Brilliant Green Bile Broth (BGBB) is used for the confirmation of coliforms and thermotolerant coliforms in food products, water used for watering food products and for effluent / run-off water testing. It can also be used as an enumeration media for coliforms in frozen dairy and ice cream products.
Packaging
Ready-to-use medium :
BM01108 – 50 tubes of 10 mL (simple concentration with Durham tubes)
Dehydrated medium :
BK002HA – 500 g bottle
Bromocresol Purple Lactose Broth

Bromocresol Purple (BCP) Lactose broth is used as enrichment media for the enumeration of coliforms and of thermotolerant coliforms in water.
Packaging
Dehydrated medium :
BK119HA – 500 g bottle
Bryant & Burkey Broth With Resazurin (Modified Bergere)

Bryant and Burkey Broth with Resazurin (modified by Bergère) is used to enumerate the spores of lactate fermenting Clostridium in milk and dairy products. In particular, it is used to detect Clostridium tyrobutyricum, responsible for the late blowing of cheeses such as gruyère, emmental, gouda, edam, cheddar or parmesan. The phenomenon arises from a high number of spores in the milk used to prepare the cheese. This number depends above all on the type of food given to the animals, since the main source of contamination is silage.
Packaging
Dehydrated medium :
BK141HA – 500 g bottle
BK141GC – 5 kg drum
Buffered Peptone Water

Buffered Peptone Water is a general use diluent destined for numerous operations and standards including sample preparation, the preparation of stock suspensions and serial dilutions of samples.
This media is also used for the pre-enrichment of Salmonella and for Cronobacter sakazakii, by allowing the resuscitation of microorganisms having undergone sublethal treatments as in the case of spray drying, pasteurization, action of conservators, elevated osmotic pressure and high acidity.
It is used as a suspension and resuscitation media for the enumeration of Listeria monocytogenes.
Packaging
Ready-to-use medium:
BM05608 – 50 tubes of 9 mL
BM05708 – 10 vials of 90 mL
BM01008 – 10 vials of 225 mL
BM13108 – 3 flexible bags of 3 L
BM13208 – 2 flexible bags of 5 L
BM21408 – 40 flexible bags of 5 L
Dehydrated medium (20.0 g/L):
BK131HA – 500 g bottle
BK131GC – 5 kg drum
Dehydrated medium (25.5 g/L):
BK018HA – 500 g bottle
BK018GC – 5 kg drum
Buffered Peptone Water Halal (BPW Halal)

Buffered Peptone Water is a general use diluent destined for numerous operations and standards including sample preparation, the preparation of stock suspensions and serial dilutions of samples (standard ISO 6887).
This media is also used for the pre-enrichment of Salmonella and for Cronobacter sakazakii, by allowing the resuscitation of microorganisms having undergone sublethal treatments as in the case of spray drying, pasteurization, action of conservators, elevated osmotic pressure and high acidity (NF EN ISO 6579-1, ISO 22964…).
The medium is certified Halal by Halal Feed and Food Inspection Authority (HFFIA), The Hague, Netherlands.
Packaging
Dehydrated media :
BK242HA – 500 g bottle
BK242GC – 5 kg drum (on demand)
Buttiaux-Brogniart Hypersalted Broth (Double Concentration)

Buttiaux-Brogniart Hypersalted Broth is a double strength enrichment medium for the detection of Staphylococcus aureus in food products, particularly in gelatin used for food and other uses.
Packaging
Dehydrated medium :
BK081HA – 500 g bottle
CFC Agar
CFC Agar is a selective medium for the enumeration of Pseudomonas spp. that frequently contaminates meats and poultry-based products during their cold storage.
The typical composition responds to the standard NF EN ISO 13720, for the enumeration of presumptive Pseudomonas in meats and meat-based products.
Packaging
Dehydrated medium :
BK082HA – 500 g bottle
Chloramphenicol Glucose Agar

Chloramphenicol Glucose Agar is destined for the detection and enumeration of yeasts and molds in food products.
The typical composition responds to that defined in the standards NF V08-059, ISO 6611 and NF EN 15789.
Packaging
Ready-to-melt medium :
BM02108 – 10 vials of 100 mL
BM07908 – 10 vials of 200 mL
Dehydrated medium :
BK007HA – 500 g bottle
Chloramphenicol Selective Supplement 50 Mg

The Chloramphenicol Selective Supplement 50 mg, supplied as a lyophilized preparation, inhibits the development of most bacterial contaminants, thereby favoring the isolation of yeasts and molds.
The supplement can substitute for the Oxytetracycline supplement recommended in the routine
The supplement can also be added to Sabouraud Agar, (BK025), to obtain Sabouraud Chloramphenicol Agar, which also exists in complete dehydrated form (BK007).
Packaging
Freeze-dried supplement:
BS02108 – 10 vials
Cronobacter Isolation Agar (CCI)
CCI Agar is used for the detection of Cronobacter spp. in food products and ingredients intended for human consumption and the feeding of animals. It is also used for the control of production environmental samples.
CCI Agar is used in particular for the detection of Cronobacter sakazakii and spp. in milk powder, dehydrated products and their components found in infant foods.
The type composition of the Chromogenic Cronobacter Isolation Agar conforms to the formulation found in the directive ISO 22964.
Packaging
Ready-to-use medium:
BM15408 – 20 Petri plates Ø 90 mm
Dehydrated medium:
BK200HA – 500 g
Coagulase Rabbit Plasma

Rabbit Plasma recovered over EDTA and freeze-dried is used for the detection of staphylocoagulase.
Its use is recommended in the standards NF EN ISO 6888-1 & NF EN ISO 6888-3; NF V08-057-1; and NF EN ISO
22718.
Packaging
Freeze-dried supplement:
BR00208 – 10 vials (20 reactions per vial)
COMPASS® Bacillus Cereus Agar & COMPASS® Bacillus Plus Agar
COMPASS® Bacillus cereus Agar is a solid medium used for the detection and the enumeration of spores and vegetative forms of presumptive species belonging to the group Bacillus cereus in products destined for human and animal consumption.
Detection or enumeration can be performed directly on this medium without purification steps, biochemical confirmation (glucose fermentation, Voges-Proskauer, nitrate reduction and hemolysis testing) and/or microscopic examination normally done within the confines of standardized methods (notably, ISO 7923 and ISO 21871).
COMPASS® Bacillus Plus Agar is obtaine by adding nutritive supplement to COMPASS® Bacillus cereus Agar. This media permit to reduce the incubation time to 21h and it allows too the recovery of all strains of the Bacillus cereus group, including Bacillus cytotoxicus.
COMPASS® Bacillus cereus Agar and COMPASS® Bacillus Plus Agar are certified NF VALIDATION for the enumeration of Bacillus cereus group bacteria, without confirmation of colonies under the reference number BKR 23/06-02/10, of which the validity runs until February 5th, 2025.
Packaging
Ready-to-use medium:
BM12608 – 20 Petri plates Ø 90 mm (COMPASS Bacillus cereus Agar
BM21308 – 20 Petri plates Ø 90 mm (COMPASS Bacillus Plus Agar)
Ready-to-melt base medium:
BM13008 – 10 vials of 100 mL
Selective supplement:
BS06908 – 10 vials qsp 100 mL
BS08508 – 10 vials qsp 500 mL
Dehydrated base medium:
BK189HA – 500 g bottle
Nutritive Supplement: Sterile Egg Yolk Emulsion for COMPASS Bacillus Plus Agar:
BS06608 – 10 vials of 50 mL
Complete Supplement Bacillus Plus
BS09808 – 10 vials of 50 mL
COMPASS® ECC Agar
The chromogenic media COMPASS® Ecc Agar is a selective agar for the simultaneous and specific enumeration without confirmation of E. coli and of other coliform bacteria in human and animal food.
Dehydrated medium:
BK202HA – 500 g bottle
COMPASS® Enterococcus Agar
COMPASS® Enterococcus Agar is a selective media used for the enumeration of enterococci in food and water.
Ready-to-use medium:
BM15708 – 20 Petri plates Ø 55 mm
Ready-to-melt medium:
BM11608 – 10 vials of 100 mL
Dehydrated medium:
BK183HA – 500 g bottle
COMPASS® Listeria Agar
ISO 16140-2 validated alternative method for the detection of Listeria monocytogenes and Listeria spp.
COMPASS® Listeria is a rapid alternative method used for the detection of Listeria monocytogenes and of Listeria
spp. in food products, and in environmental samples.
It features a single step of selective enrichment in Fraser ½ broth, followed by subculture onto COMPASS® Listeria
Agar. Enrichment can be performed at 37°C for 18 to 24 hours, or at 30°C for 22 to 28 hours.
This method is certified NF VALIDATION, according to the validation protocol NF EN ISO 16140-2 of 2016 for all
human food products and samples from the industrial production environment. The reference method used for the
validation is the standard NF EN ISO 11290-1 of 2017.
The method is certified NF VALIDATION, under Attestation N° BKR 23/02-11/02.
Please refer to the COMPASS LISTERIA AGAR_VALIDATED METHOD_BK192HA_BM12308_BM12408_BS07008_BS07108_BT00808
ISO 16140-2 validated alternative method for the enumeration of Listeria monocytogenes
The COMPASS® Listeria method is also used as a rapid alternative method for the enumeration of L. monocytogenes
in human food products and environmental samples, by surface or deep plating.
The method is certified NF VALIDATION, under Attestation N° BKR 23/05-12/07.
Please refer to the COMPASS LISTERIA AGAR_VALIDATED METHOD_BK192HA_BM12308_BM12408_BS07008_BS07108_BT00808
Normalized method for the detection and enumeration of Listeria monocytogenes et Listeria spp.
The formulation of the COMPASS® Listeria Agar corresponds to that recommended in the international standards NF
EN ISO 11290-1 and NF EN ISO 11290-2.
COMPASS® Listeria Agar is the first mandatory isolation medium in the L. monocytogenes and Listeria spp. detection
protocol, and the only medium in the L. monocytogenes and Listeria spp. enumeration protocol.
The formulation of the COMPASS® Listeria Agar also corresponds to Agar Listeria according to Ottaviani and Agosti in the Chapter 10 of FDA’s Bacteriological Analytical Manual (FDA-BAM).
Please refer to the COMPASS LISTERIA AGAR_acc. ISO 11290
Packaging
Ready-to-use medium:
BM12308 – 20 Petri plates Ø 90 mm
BM12408 – 120 Petri plates Ø 90 mm
Kit COMPASS Listeria Agar :
BT00808 – 6 vials of 200 mL base medium + 6 vials of freeze-dried selective supplement + 6 vials of liquid enrichment supplement
Dehydrated base medium:
BK192HA – 500 g bottle
Enrichment supplement:
BS07008 – 8 vials qsp 1L
Freeze-dried selective supplement :
BS07108 – 8 vials qsp 1L
COMPASS® Salmonella Agar
COMPASS® Salmonella Agar is a selective media allowing the isolation and differentiation of bacteria belonging to the genus Salmonella.
It can be used as the second media in all normalized and validated methods for the detection of Salmonella.
COMPASS® Salmonella Agar is also used in the context of the rapid alternative method for the detection of Salmonella (SESAME Salmonella TEST®).
Packaging
Ready-to-use medium:
BM06608 – 20 Petri plates Ø 90 mm
BM23008 – 120 Petri plates Ø 90 mm
CONFIRM’ C. perfringens

CONFIRM’ C. perfringens is a rapid biochemical test designed to confirm the species Clostridium perfringens from a characteristic colony obtained directly from PERFECTO Duo® agar, as part of the alternative method to standards NF EN ISO 15213-1:2023 and NF EN ISO 15213-2:2023 for the rapid and simultaneous enumeration of Clostridium spp. and C. perfringens, respectively.
This method does not require any purification step and provides results in only 15 minutes.
Packaging
BT01708 – 50 tests ( 6 x R1, 2 x R2, 1 x R3 + trays)
BA01408 – Restock of trays (6 bags of 5 trays )
Confirm’ L. Mono Agar®
CONFIRM’ L. mono Agar® is a solid culture media designed for the confirmation of the genus & species Listeria monocytogenes, isolated from a single characteristic colony from COMPASS® Listeria Agar, within the context of the detection method (certified AFNOR Certification, under the reference number BKR 23/2-11/02 and enumeration methods (certified AFAQ AFNOR Certification under the reference number BKR 23/05-12/07).
Packaging
Ready-to-use medium:
BM13908 – 10 Petri plates Ø 90 mm
Confirm’ L. Mono Broth

The CONFIRM’ L. mono broth® is a liquid media destined for the confirmation of the genus & species Listeria monocytogenes, isolated from a single characteristic colony from COMPASS® Listeria Agar, within the context of the alternative methods for the detection and enumeration of Listeria monocytogenes certified NF VALIDATION.
Packaging
Ready-to-use medium:
BM16208 – 18 tubes of 1 mL
Confirm’ Salmonella

CONFIRM’ Salmonella is a latex agglutination test that allows for the confirmation of presumed positive colonies of Salmonella, after purification.
CONFIRM’ Salmonella is also used as a means of confirmation in the context of the rapid, alternative method of Salmonella detection (IRIS Salmonella®), without a purification step, directly from a characteristic magenta colony isolated on IRIS media.
The IRIS Salmonella® method of Salmonella detection is certified by AFNOR Certification, under Attestation N° BKR 23/07 – 10/11.
Packaging
KIT :
BT01108 – Kit for 50 tests with Reagent R1 (Latex test) + Solution R2 (Positive Control) + Solution R3 (Negative Control) + disposable agglutination slides + disposable mixing batons.
Contact Baird-Parker + Neutralizers

Baird-Parker agar with potassium tellurite egg yolk, supplemented with neutralizers, is a ready-to-use media. The media is used for the detection and enumeration of Staphylococcus aureus present on surfaces by impression on agar to control critical points in industry (examples: protected areas, microbiological monitoring programs of surfaces and industrial environments).
Packaging
Ready-to-use medium :
BM21108 – 20 plates of Ø 65mm
Contact PCA + TTC + Neutralizers
Plate Count Agar (PCA) supplemented with TTC and neutralizers is a ready-to-use media. The media is used for the detection and enumeration of microorganisms present on surfaces by impression on agar to control critical points in industry (examples: protected areas, microbiological monitoring programs of surfaces and industrial environments).
Packaging
Ready-to-use medium :
BM20608 – 20 plates of Ø 65mm
Contact Sabouraud With Chloramphenicol (SDCA) + Neutralizers
Sabouraud with Chloramphenicol Agar, supplemented with neutralizers, is a ready-to-use media. The media is used for the detection and enumeration of yeasts and molds present on surfaces by impression on agar to control critical points in industry (examples: protected areas, microbiological monitoring programs of surfaces and industrial environments).
Packaging
Ready-to-use medium :
BM21008 – 20 plates of Ø 65mm
Contact VRBG + Neutralizers
VRBG agar (Violet Red Bile Glucose/Dextrose) with neutralizers is a ready-to-use media. The media is used for the detection and enumeration of Enterobacteriaceae, but also for the detection of Gram-negative and bile salt resistant bacteria present on surfaces by impression on agar to control critical points in industry (examples: protected areas, microbiological monitoring programs of surfaces and industrial environments).
Packaging
Ready-to-use medium :
BM20708 – VRBG – 20 plates of Ø 65mm
Contact VRBL + Neutralizers
VRBL agar (Violet Red Bile Lactose) with neutralizers is a ready-to-use media. The media is used for the detection and enumeration of coliforms and thermotolerant coliforms present on surfaces by impression on agar to control critical points in industry (examples: protected areas, microbiological monitoring programs of surfaces and industrial environments).
Packaging
Ready-to-use medium :
BM20908 – VRBL – 20 plates of Ø 65mm
Cronobacter Screening Broth (CSB)

Cronobacter Screening broth is a selective enrichment media used for the detection of Cronobacter spp. in food products and ingredients intended for human consumption and the feeding of animals. It is also used for the control of production environmental samples.
The typical composition responds to that defined in the standard ISO 22964.
Packaging
Ready-to-use medium:
BM15508 – 50 tubes of 10 mL
CSD Method
The CSD method allows the rapid detection of Cronobacter spp in human food products (especially milk powders and infant ingredients) and products from the production environment.
At the end of an enrichment phase with Salmonella Enrichment + CSD supplement, a subculture is carried out on CCI agar. The characteristic colonies will be confirmed.
The CSD method is NF VALIDATION certified, for the detection of Cronobacter spp, according to the validation protocol NF EN ISO 16140-2 of 2016, for the following categories:
– Infant milk powders, with and without probiotics; ingredients for test intakes from 0 to 50 g, with a 1/10th dilution.
– Infant milk powders, with and without probiotics; ingredients for test intakes from 50 to 375 g, with a ¼ dilution.
– Samples of the production environment
Refer to the certificate available on the NF VALIDATION website for the end of validity date of the method.
The reference method used for the validation is the standard EN ISO 22964 : 2017.
The CCI agar complies with the formulation described in the ISO 22964 standard of 2017.
The CSD supplement allows the common enrichment of Salmonella and Cronobacter in infant milk powders with and without probiotics, as well as ingredients and environmental products.
For the detection of Salmonella spp, refer to the IRIS method, BKR 23/07-10/11, certified NF VALIDATION.
Packaging
Salmonella Enrichment :
BK194HA – 500 g bottle
BK194GC – 5 kg drum
BM13608 – 10 x 225 mL vials
BM13708 – 3 x 3 L flexible bags
BM14408 – 2 x 5 L flexible bags
BM23708 – 40 x 5 L flexible bags
Salmonella Enrichment + Tween® 80 (10 g/L):
BM16308 – 3 x 3 L flexible bags
BM19808 – 2 x 5 L flexible bags
BM21608 – 10 x 225 mL vials
Salmonella Enrichment double-strength buffered:
BK225HA – 500 g bottle
BK225GC – 5 kg drum
BM20008 – 2 x 5 L flexible bags
BM20108 – 10 x 225 mL vials
Salmonella Enrichment 9X Concentrated:
BM23308 – 4 x 2.5 L flexible bag
Gélose CCI (Ø 90 mm):
BM15408 – 20 plates (Ø 90 mm)
BM22608 – 120 plates (Ø 90 mm)
Supplément CSD:
BS09508 – 10 x 100 mL vials
BS09908 – Tablets qsf 10 g
BS10008 – Tablets qsf 25 g